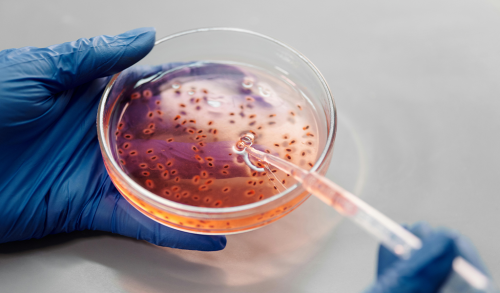

UAH | Gyncana científica: construye tu propio biorreactor
Aforo completo
Organizador
Horario
Viernes 27 de septiembre, a las 18:00 y 19:15
Lugar
Facultad de Ciencias. Campus científico tecnológico de la Universidad de Alcalá
Público al que va dirigido
Público infantil y primaria
Colaboradores
Tras una charla de introducción a las Tecnologías Electroquímicas Microbianas y sus aplicaciones, los asistentes se reunirán en equipos para encontrar las pistas que conduzcan a la obtención de todos los elementos necesarios para construir su propio biorreactor, un dispositivo capaz de transformar materia orgánica en energía eléctrica por medio de microorganismos electroactivos.
ACTIVIDAD DIRIGIDA A MENORES DE MENORES DE 9 A 12 AÑOS




